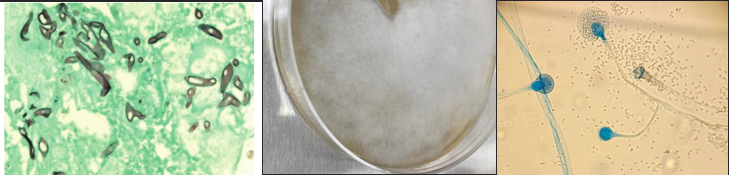
<p><span style="font-family: &quot;Times New Roman&quot;, serif; line-height: 107%;"><span>Classical association: bovine abortion (“mucormycosis”)</span></span></p><p class="MsoListParagraphCxSpMiddle"><span style="font-family: &quot;Times New Roman&quot;; line-height: normal; font-size: 7pt;"><span> </span></span><span style="font-family: &quot;Times New Roman&quot;, serif; line-height: 107%;"><span>Histology: aseptate broad hyphae, irregular width, wide angle branching</span></span></p><p class="MsoListParagraphCxSpMiddle"><span style="font-family: &quot;Times New Roman&quot;, serif; line-height: 107%;"><span>Culture: fluffy mould on Sam</span></span></p><p class="MsoListParagraphCxSpLast"><span style="font-family: &quot;Times New Roman&quot;, serif; line-height: 107%;"><span>Microscopy: sporangium filled with sporangiospores</span></span></p><p class="MsoListParagraphCxSpLast"><span style="font-family: &quot;Times New Roman&quot;, serif; line-height: 107%;"><span>What is it?</span></span></p>
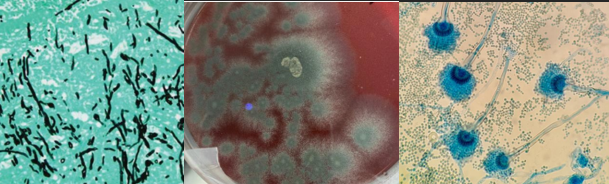
<p><span style="font-family: &quot;Times New Roman&quot;, serif; line-height: 107%;"><span>Classical association: bovine abortion; nasal aspergillosis in dogs</span></span></p><p class="MsoListParagraphCxSpMiddle"><span style="font-family: &quot;Times New Roman&quot;, serif; line-height: 107%;"><span>Histology: septate, parallel walls, 45° dichotomous branching</span></span></p><p class="MsoListParagraphCxSpMiddle"><span style="font-family: &quot;Times New Roman&quot;, serif; line-height: 107%;"><span>Culture: powdery/velvety mould</span></span></p><p class="MsoListParagraphCxSpLast"><span style="font-family: &quot;Times New Roman&quot;, serif; line-height: 107%;"><span>Microscopy: conidiospores</span></span></p><p class="MsoListParagraphCxSpLast"><span style="font-family: &quot;Times New Roman&quot;, serif; line-height: 107%;"><span>What is it?</span></span></p>
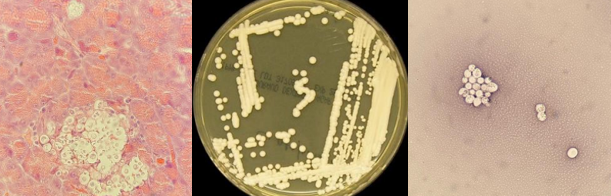
<p><span style="font-family: &quot;Times New Roman&quot;, serif; line-height: 107%;"><span>Clinical association: cats (pneumonia, CNS, nasal masses); most common systemic fungal pathogen in cats</span></span></p><p class="MsoListParagraphCxSpMiddle"><span style="font-family: &quot;Times New Roman&quot;, serif; line-height: 107%;"><span>Histology: soap bubble appearance due to the capsule</span></span></p><p class="MsoListParagraphCxSpMiddle"><span style="font-family: &quot;Times New Roman&quot;, serif; line-height: 107%;"><span>India ink: shows thick capsule</span></span></p><p class="MsoListParagraphCxSpLast"><span style="font-family: &quot;Times New Roman&quot;, serif; line-height: 107%;"><span>Culture: small, mucoid colonies</span></span></p><p class="MsoListParagraphCxSpLast"><span style="font-family: &quot;Times New Roman&quot;, serif; line-height: 107%;"><span>What is it?</span></span></p>
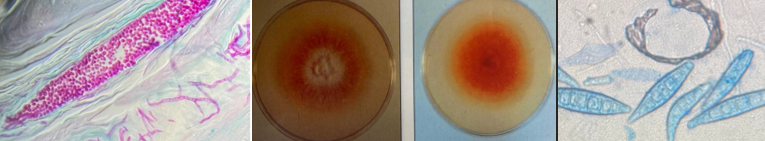
<p><span style="font-family: &quot;Times New Roman&quot;, serif; line-height: 107%;"><span>Clinical associations: ringworm (dogs, cats = M. canis; cattle = T. verrucosum)</span></span></p><p class="MsoListParagraphCxSpMiddle"><span style="font-family: &quot;Times New Roman&quot;, serif; line-height: 107%;"><span>Histology (PAS): arthroconidia on/outside hair (ectothrix)(bring pink/red staining arthrospores called arthroconidia outside hair shaft)</span></span></p><p class="MsoListParagraphCxSpMiddle"><span style="font-family: &quot;Times New Roman&quot;, serif; line-height: 107%;"><span>KOH prep: clear keratin </span></span><span style="line-height: 107%;"><span>à</span></span><span style="font-family: &quot;Times New Roman&quot;, serif; line-height: 107%;"><span> reveals fungal arthrospores</span></span></p><p class="MsoListParagraphCxSpMiddle"><span style="font-family: &quot;Times New Roman&quot;, serif; line-height: 107%;"><span>Culture (SAB-CC): selective fro dermatophytes</span></span></p><p class="MsoListParagraphCxSpLast"><span style="font-family: &quot;Times New Roman&quot;, serif; line-height: 107%;"><span>Microscopy: M. canis = spindle macroconidia with terminal knob</span></span></p><p class="MsoListParagraphCxSpLast"><span style="font-family: &quot;Times New Roman&quot;, serif; line-height: 107%;"><span>What is it?</span></span></p>

Bacteriology Lab Exam - Fungi
1/9
Earn XP
Description and Tags
Year 2 Semester 1
Name | Mastery | Learn | Test | Matching | Spaced |
|---|
No study sessions yet.
10 Terms
HX: opportunistic, white plaques (thrush), curd-like vaginal discharge, mastitis
Morphology: budding yeasts
What is it?

candida albicans
HX: chronic, antibiotic unresponsive bovine mastitis
What is it?

NOT BACTERIA; NOT FUNGI - Prototheca zopfii (ALGAE)
Classical association: bovine abortion (“mucormycosis”)
Histology: aseptate broad hyphae, irregular width, wide angle branching
Culture: fluffy mould on Sam
Microscopy: sporangium filled with sporangiospores
What is it?
Mucor species
class: zygomycetes aseptate fungi
Classical association: bovine abortion; nasal aspergillosis in dogs
Histology: septate, parallel walls, 45° dichotomous branching
Culture: powdery/velvety mould
Microscopy: conidiospores
What is it?
aspergillus fumigatus
Clinical association: cats (pneumonia, CNS, nasal masses); most common systemic fungal pathogen in cats
Histology: soap bubble appearance due to the capsule
India ink: shows thick capsule
Culture: small, mucoid colonies
What is it?
Cryptococcus neoformas

Clinical association: NA dogs with coccidiodomycosis will have a history of travel to western USA or Mexico where this species is endemic
This stain is from a lung preparation from a dog
Has two forms – mould or yeast (aka thermally dimorphic fungi)
Mould form (25C): septate hyphae
Yeast/Spherule form (37C): huge spherules with endospores
What is it?
Coccidioides immitis

Clinical association: systemic infection found in macrophages
Has two forms – mould or yeast (aka thermally dimorphic fungi)
Mould form (25C): septate hyphae, tuberculate chlamydospores
Yeast/spherule form (37C): small intracellular yeasts
Considered a Risk Group 3 fungal agent
What is it?
Histoplasma capsultatum
Commonly isolated from cases of otitis externa and dermatitis in dogs. It is thought to be an opportunist pathogen, since it may be found in low numbers, in the ears and on the skin of normal healthy dogs
gram stain smear of a case of chronic otitis externa in dog
peanut/boot print/bowling ball shaped
What is it?

Malassezia pachydermatis

Clinical application: histology of canine with pneumonia, but can be in lungs (transtracheal aspirates), skin (exudates/aspirates), and brain (CSF)
Has two forms – mould or yeast (aka thermally dimorphic fungi)
Mould form (25C): septate hyphae
Yeast/spherule form (37C): large yeasts, thick wall, broad-based budding
Blastomyces dermatitidis
Clinical associations: ringworm (dogs, cats = M. canis; cattle = T. verrucosum)
Histology (PAS): arthroconidia on/outside hair (ectothrix)(bring pink/red staining arthrospores called arthroconidia outside hair shaft)
KOH prep: clear keratin à reveals fungal arthrospores
Culture (SAB-CC): selective fro dermatophytes
Microscopy: M. canis = spindle macroconidia with terminal knob
What is it?
Microsporum canis (aka dermatophytes - ringworm)